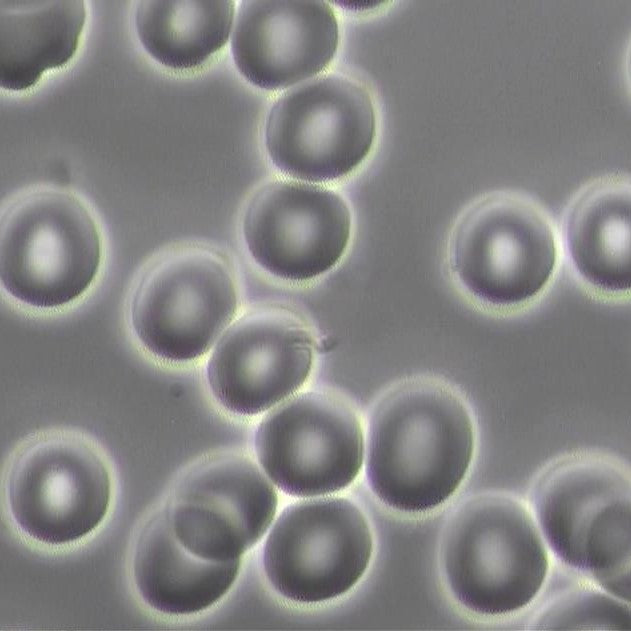

Omnia's Test Results
We present these 5 Test Results so you can see the body's response and understand the performance benefits we have recorded thanks to the Omnia Radiation Balancer. By testing across a range of modalities, we can triangulate our results to give a rounded picture of the benefit. However, our results are subjective and open to your interpretation in terms of the level of protection offered.
Our methodology is to take a baseline reading of the body (or water), then measure the body's response after exposure to EMF, and to then repeat the same test with an ORB on the wireless device (or the pendant worn) to see if we observe a difference.
The HRV, Applied Kinesiology and Water Crystal Photography tests are independent tests, whereas the Live Blood Analysis was performed in a laboratory with the Omnia founder as the test candidate.
Clinical Tests

Heart Rate Variability
How is heart rate impacted by radiating devices? Does the Omnia's technology lead to an improvement of heart rate variability?

Water Crystal Photography
Does water’s structure change when it is exposed to 5G Wireless Radiation? Did we observe hexagonal, crystalline structure when the ORB was applied?
Live Blood Analysis
Can watching a video on a mobile phone for 20 minutes affect the blood cells? Does the blood return to balance and a normal shape once the ORB is applied?.
Body / Energy Tests
Try these at home and see if you notice a difference

Applied Kinesiology
Is the strength and electrical balance of the body compromised when holding a cell phone? Does muscle strength improve when the ORB is applied?

Range of Motion
Is the body's flexibility affected when we are in direct contact with a radiating device? Can the ORB help to restore full range of body motion?

Other Omnia Tests
We continue to perform tests that prove that our products work, although some modalities will not let us use their results.




Share and get 15% off!
Simply share this product on one of the following social networks and you will unlock 15% off!